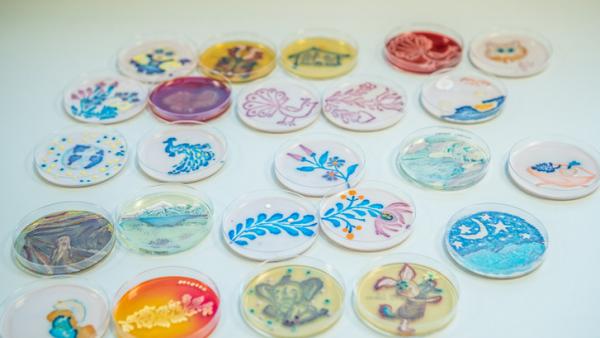
forrás: Index.hu

Egy órán belül kimutatható a koronavírus egy új eszközzel
A fertőző légúti betegségek akár 40 kórokozóját, köztük az új koronavírust és a madárinfluenza vírusát is ki lehet mutatni egy órán belül egy új eszközzel, amelynek kifejlesztését hongkongi tudósok jelentették be kedden.
2020. február 13. 12:28 | behir.hu
Tovább olvasom








-600x338.jpg)